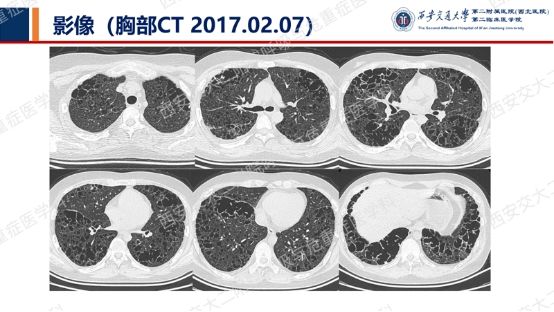

电话:029-87679000(总机)
地址:陕西省西安市西五路157号
邮编:710114
网址:www.2yuan.xjtu.edu.cn

电话:029-87679000(总机)
地址:陕西省西安市西五路157号
邮编:710114
网址:www.2yuan.xjtu.edu.cn

影像方寸藏玄机,同影异病辨真章。第三期我们又给大家提供了一例肺部囊性病变的病例,只是不同于前两期的BHD,也不是LAM,也并非LIP。到底是什么呢?让我们一起析病寻踪,深挖疾病真相,共探诊疗核心!
析病寻踪




这名大学生起先的症状是多饮多尿,时隔2年才出现呼吸系统症状——干咳,后反复胸闷、气短。胸部CT提示“两肺呈淡薄片状磨玻璃改变,同时可见多发类圆形无肺纹理透亮区”,后并发气胸,气胸好转后再复查胸部CT,提示“双肺弥漫性间质改变,双肺多发空腔性病变,较前进展、部分融合”。
相信有以上病史和胸部影像学资料,大家已经有了答案。让我继续看看实验室检查结果:血常规、粪常规、肝肾功电解质心肌酶、凝血功能等未见明显异常,血沉40mm/h,C反应蛋白及降钙素原、G试验及GM试验均阴性,结核相关检查阴性,肿瘤标志物未见明显异常,CTD相关检查阴性。
尿常规提示尿比重低下(1.000),甲功TSH略高(6.06 uIU/ml),皮质醇升高(667.10 nmol/L),性激素六项均低下(E2 <5.00 pg/ml、FSH 0.70 mIU/ml、PRL 18.21 ng/ml、TESTO 21.36 ng/dl)。
血气分析:pH 7.453,pCO2 35.6mmHg,pO2 67.4mmHg,SO2 93.9%。肺功能提示混合性通气功能障碍(FEV1/FVC 69.04,FEV1%pred 35.3),弥散功能减低,支气管舒张试验阴性。心脏及腹部超声检查未见明显异常。全身骨骼X线片未见异常。

综合以上病史和资料,患者多尿多饮并干咳、胸闷、气短,反复气胸,尿比重低下,激素水平异常,胸部CT提示“肺间质改变、多发囊性病变”,垂体MR增强提示“垂体柄增粗并强化不均匀”,最终诊断:多系统朗格汉斯细胞组织细胞增生症(MS-LCH)。
诊疗启示
从看似寻常的肺部囊性病变,到抽丝剥茧锁定多系统朗格汉斯细胞组织细胞增生症,我们再次见证了“同影异病”的诊疗魅力。至此,肺部弥漫性囊性病变中最常见的LAM、BHD、LIP、PLCH等疾病,我们都做出了系列展示和分析,一方面考验阅片能力,需要以影识病,一方面也需要结合多系统症状、实验室检查综合判断,才能精准明确诊断。

临床诊疗之路道阻且长,唯有将影像学特征与多系统症状、实验室检查深度融合,方能拨开迷雾,直击病源。期待下一期,我们继续以影为钥,共探呼吸疾病的诊疗秘境!